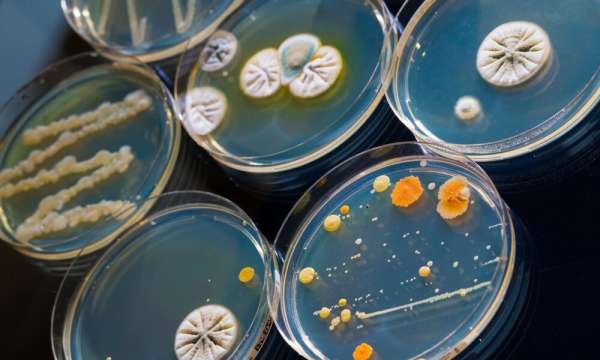
Read more about the article Анализ морфологии ооцит-кумулюсных комплексов Sus scrofa domesticus, подвергшихся воздействию низких и сверхнизких температур

Циркуляция вируса гриппа типа А среди вороновых на территории Северного Казахстана
Грипп птиц, вызываемый вирусами гриппа типа А, продолжает представлять глобальную угрозу для здравоохранения, птицеводства и дикой фауны. Высокопатогенные штаммы, такие как H5N1 и H5N8, способны вызывать массовую гибель домашних и диких птиц и тяжелые инфекции у людей с летальностью до 60%.
Основным природным резервуаром вируса являются водоплавающие и околоводные птицы, формирующие эпизоотические очаги в местах массовых скоплений на водоемах.
В последние годы отмечается рост заболеваемости гриппом птиц в мире, в том числе с вовлечением новых видов и территорий. Так, в 2020–2022 годах крупные вспышки высокопатогенного гриппа H5N1 и H5N8 были зарегистрированы среди домашних и диких птиц в десятках стран Азии, Европы и Африки. Эти события демонстрируют исключительную изменчивость вируса гриппа и его способность преодолевать межвидовые барьеры.
Источник и фото: Аграрная наука
Источник: https://agronovosti.ru/czirkulyacziya-virusa-grippa-tipa-a-sredi-voronovyh-na-territorii-severnogo-kazahstana/
 agronom-nauka.ru
agronom-nauka.ru